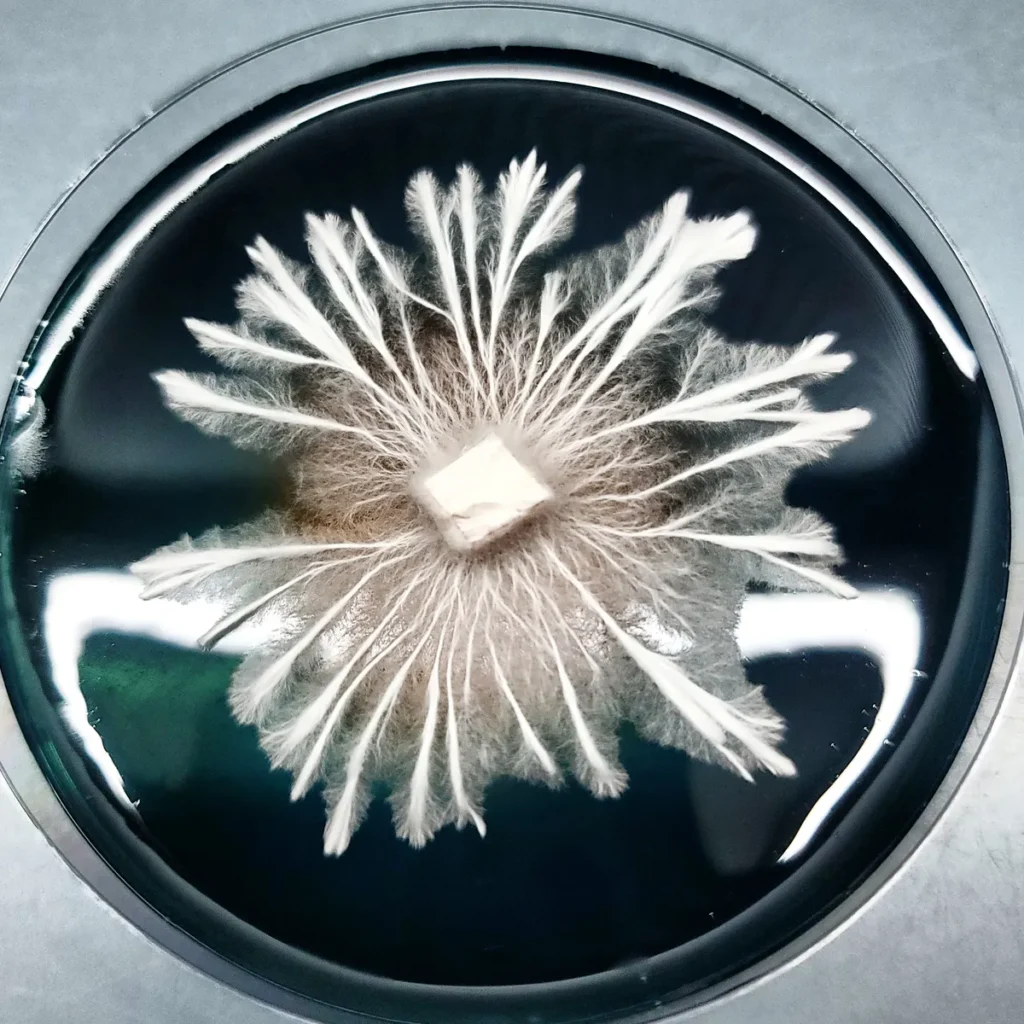

The Chemistry of Psilocybin: Evolution’s Mysterious Creation
Welcome, fellow mycology enthusiasts. Today, let’s explore the fascinating chemistry of psilocybin, a compound produced by certain fungi. This molecule not only sparks human curiosity but also reveals some of evolution’s cleverest secrets about adaptation and survival. Why would mushrooms evolve to make it? And what role does it play in their world? Join me as we examine the chemistry and evolutionary story behind this mysterious metabolite.

What Is the Chemistry of Psilocybin?
Psilocybin is a naturally occurring secondary metabolite. In biology, secondary metabolites are compounds that do more than sustain basic growth. Instead, they often act as tools for survival. Plants and fungi use them for defense, competition, or communication within their ecosystems.

Psilocybin stands out among these compounds. It is complex, unusual, and has few clear analogs in the natural world. Research suggests it arose from simpler building blocks. Over time, fungi refined it through biochemical innovation, crafting a molecule with very specific properties.
From Tryptamine to Psilocybin
At its core, psilocybin is derived from tryptamine. Tryptamine is a common amino acid derivative and also a precursor to serotonin in animals. In fungi, a unique enzymatic pathway alters this base. Specialized enzymes add phosphate groups, stabilizing the molecule and creating psilocybin.
When mushrooms are eaten or broken down, psilocybin converts into psilocin. This happens through a simple enzymatic process called dephosphorylation. Psilocin is the active metabolite and the one that affects nervous systems. For fungi, this reaction may have offered a clever defense. The altered behavior of insects or animals after ingestion could discourage further feeding, protecting the mushrooms from harm.

Why Would Mushrooms Evolve Psilocybin?
The question remains: why invest energy in making psilocybin at all? Scientists have proposed several theories. One of the strongest ideas is chemical defense. By altering the behavior or perception of predators, psilocybin may reduce the chances of being eaten. Less predation means more time to release spores and ensure survival.
Another hypothesis looks beyond predators. Psilocybin may also influence the soil microbiome. Fungi live in constant exchange with bacteria and other organisms. If psilocybin shapes these interactions, it could create more favorable conditions for growth. Altered bacterial activity might enrich the soil, indirectly supporting fungal survival.
Both ideas highlight psilocybin as an adaptive tool. Whether deterring predators or managing microbial communities, the compound provides benefits that outweigh the metabolic cost of producing it.

A Glimpse into Fungal Evolution
Studying psilocybin offers a glimpse into fungi’s deep evolutionary history. Specialized metabolites like this one reflect millions of years of adaptation. Each represents a response to pressure, whether from predators, competitors, or shifting ecosystems.
Fungi have always been innovators. They co-evolved alongside plants, insects, and animals. Each interaction pushed them to develop new strategies for survival. Psilocybin is one of many examples. Like antibiotics, mycotoxins, or pigments, it shows how fungi respond creatively to the challenges of life.
This diversity of chemical solutions is one reason fungi remain so resilient. Their adaptability explains why they thrive in forests, deserts, and even urban landscapes.
Beyond Human Curiosity
Humans are fascinated by psilocybin, but we must remember that its origins are not about us. Its role lies within the fungal kingdom itself. The structure and stability of psilocybin, along with its strange interactions, continue to puzzle researchers. Yet each discovery offers another layer of understanding.
By studying psilocybin, scientists uncover lessons about adaptation, survival, and ecological balance. These lessons may eventually help us see how compounds shape entire ecosystems. Psilocybin is not just a molecule; it is part of a larger network of relationships that sustain life.
A Closing Thought
The evolution of psilocybin reminds us of nature’s endless creativity. Each metabolite, no matter how strange, tells a story of survival. For fungi, psilocybin may have served as both shield and tool. For us, it is a window into hidden biochemical worlds.
As we continue to explore these molecules, we are invited to look deeper into the living soil beneath our feet. Every chemical pathway is a thread in the web of life, and every organism depends on countless such threads for balance. Psilocybin is one thread among thousands, yet it has captured human imagination in a powerful way.
The mystery of psilocybin is still unfolding. What we know today may only be the first chapter in a story written by evolution over millions of years.
